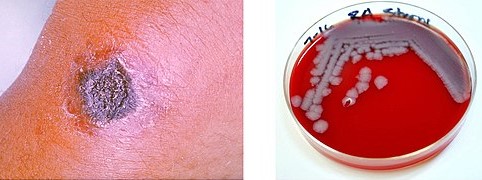
OSC_Microbio_21_02_anthrax.jpg

PUMPA - SMART LEARNING
எங்கள் ஆசிரியர்களுடன் 1-ஆன்-1 ஆலோசனை நேரத்தைப் பெறுங்கள். டாப்பர் ஆவதற்கு நாங்கள் பயிற்சி அளிப்போம்
Book Free DemoThe potential to cause injury, ill-health, or damage to human beings and their property or environment is known as a hazards.
Hazards in the silk industry:
As the silk industry workers stand for a long time to reel the silk into yarn, they are mostly affected with arthritis. They also develop problems such as back pain, skin injuries, and creative problems.
As their work area is poorly ventilated, they also suffer from respiratory problems such as asthma and bronchitis.

Asthama

Bronchitis
When the workers are constantly exposed to the boiling of cocoons, the skin becomes raw and blistered, leading to the peeling of the skin of hands and feet, leading to diseases like scabies.
Hazards in the wool industry:
When the workers are exposed to various chemicals and detergents in the wool industry, the exposure causes allergies to the skin.
People working in this industry can also get infected by an anthrax bacterium that causes a fatal blood disease called Sorter disease.
Anthrax and Bacillus anthracis
Anthrax is caused by Bacillus anthracis due to handling contaminated hair and contact with livestock during hair processing.
The symptoms of this disease include fever, cough, and shortness of breath, similar to pneumonia. At some times, it also causes nausea, vomiting, and diarrhoea.
Treatment:
- In order to treat anthrax, Penicillin or Ciprofloxacin is given as the best medicine.
- In order to prevent the spreading of the disease, either the animals are to be vaccinated or the infected animal's carcases are to be buried or burnt.
- It is mandatory that the employer takes care of industrial workers, provide them with a hygienic and well-ventilated place to work.
Ahimsa silk:
It is also known as peace silk. In Hindi, the word Ahimsa means non-violence. It is a method of non-violent silk breeding and harvesting.
Kusuma Rajaiah, a Government officer from the Andhra Pradesh state of India, proposed the ahimsa way of silk production in \(1992\). This is a method in which silk is made without killing the silkworms. It is a humane method in which the worms are allowed to hatch and use vacant cocoons.

Hatched cocoon
The traditional method of silk manufacture involves boiling of cocoons of the silkworms and sorting out the threads used in the production of silk. This method has been supported by people who are interested in the welfare of animals.
Reference:
https://upload.wikimedia.org/wikipedia/commons/thumb/5/5b/Asthma_%28Lungs%29.png/512px-Asthma_%28Lungs%29.png
https://upload.wikimedia.org/wikipedia/commons/thumb/1/1c/Bronchitis.png/512px-Bronchitis.png
https://commons.wikimedia.org/wiki/File:Cut-cocoon.jpg
https://upload.wikimedia.org/wikipedia/commons/thumb/f/fb/OSC_Microbio_21_02_anthrax.jpg/512px-OSC_Microbio_21_02_anthrax.jpg